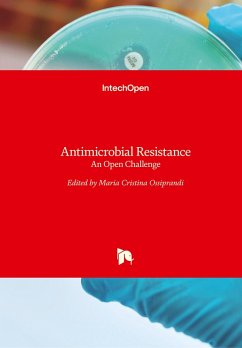
Cover Antimicrobial Resistance

Antimicrobial Agents
Versandkostenfrei!
Versandfertig in 1-2 Wochen
101,99 €
inkl. MwSt.

PAYBACK Punkte
51 °P sammeln!
This book contains precisely referenced chapters, emphasizing antibacterial agents with clinical practicality and alternatives to synthetic antibacterial agents through detailed reviews of diseases and their control using alternative approaches. The book aims at explaining bacterial diseases and their control via synthetic drugs replaced by chemicals obtained from different natural resources which present a future direction in the pharmaceutical industry. The book attempts to present emerging low cost and environmentally friendly drugs that are free from side effects studied in the overlapping...
This book contains precisely referenced chapters, emphasizing antibacterial agents with clinical practicality and alternatives to synthetic antibacterial agents through detailed reviews of diseases and their control using alternative approaches. The book aims at explaining bacterial diseases and their control via synthetic drugs replaced by chemicals obtained from different natural resources which present a future direction in the pharmaceutical industry. The book attempts to present emerging low cost and environmentally friendly drugs that are free from side effects studied in the overlapping disciplines of medicinal chemistry, biochemistry, microbiology and pharmacology.